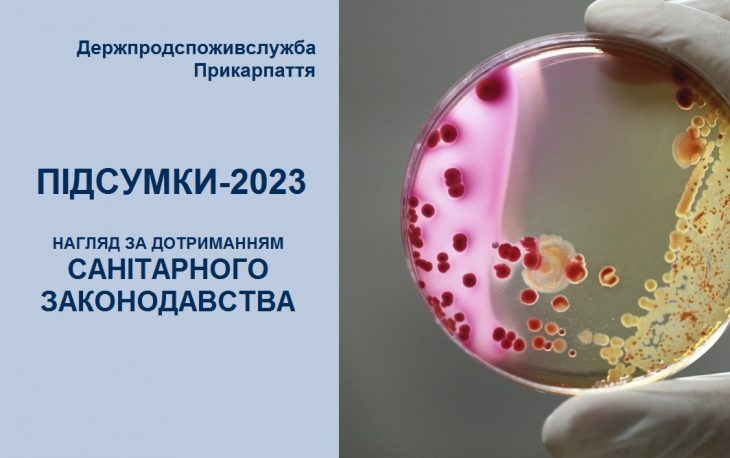

Державний нагляд за дотриманням санітарного законодавства – підсумки роботи Держпродспоживслужби Прикарпаття у 2023 році
Подаємо до уваги громадськості інформацію про основні показники виробничої діяльності за 2023 рік у сфері державного нагляду за дотриманням санітарного законодавства.
Пише Голос-Інфо з посиланням на Головне управління Держпродспоживслужби в Івано – Франківській області
Заходи щодо недопущення ускладнення епідемічної ситуації в області.
У 2023 році в Івано-Франківській області епідемічна ситуація була стабільною та контрольованою. В області зареєстровано 4 спалахи гострих кишкових інфекційних захворювань в Надвірнянському та Верховинському районах, від яких постраждали 37 осіб, в тому числі 29 дітей віком до 18 років. Спалахи реєструвалися у відпочинкових комплексах (3 приватні садиби та готельно-відпочинковий комплекс). Спеціалістами Головного управління Держпродспоживслужби в Івано-Франківській області проведено весь комплекс протиепідемічних заходів в осередках захворювань: 4 санітарно-епідеміологічні обстеження, 3 позапланові заходи державного нагляду (контролю) у сфері безпечності харчових продуктів, накладено 3 штрафи за порушення у сфері санітарного законодавства на суму 1275 грн., 1 штраф за порушення у сфері безпечності харчових продуктів на суму 765 грн., матеріали по розслідуваннях передані до Головного управління Національної поліції.
Окрім того, в області зареєстровано 3 випадки ботулізму в побуті з п’ятьма потерпілими, які виникли внаслідок вживання м’ясних консервів домашнього виготовлення та зареєстровані в Калуському, Коломийському та Верховинському районах; 7 випадків отруєнь дикорослими грибами, від яких потерпіло 9 осіб, в тому числі 4 дитини.
Випадків масових інфекційних захворювань та отруєнь, пов’язаних з водним фактором передачі, в області не реєструвалось
В 2023 році здійснено 346 моніторингових відвідувань щодо контролю за дотриманням протиепідемічних вимог в пунктах проживання та харчування внутрішньо переміщених осіб та в пунктах прийому гуманітарної допомоги, виявлено порушення у 7 пунктах проживання, надано 143 пропозиції та рекомендації щодо режимів прибирання, дезінфекційної обробки приміщень, проведення профілактичної дератизації та дезінсекції, за результатами обстежень та встановлених порушень поінформовано голів 6 територіальних громад.
Державний нагляд.
Здійснено 79 позапланових заходів державного нагляду (контролю) у сфері санітарного законодавства, з них 42 – на централізованих водопроводах, 8 – у закладах загальної середньої освіти, 6 – у дитячих оздоровчих та відпочинкових закладах, 1 – на підприємстві сільського господарства, 7 – на промислових підприємствах, 1- у перукарні, 14 – на інших об’єктах нагляду.
За результатами заходів державного нагляду: винесено 49 приписів, накладено 10 штрафів за порушення вимог санітарного законодавства, ініційовано 79 засідань регіональних та місцевих комісій з питань ТЕБ і НС.
Стан водопостачання.
В Івано-Франківській області функціонує 47 централізованих водопроводів. В 2023 році взято на облік та перевірено 8 відомчих водопроводів АТ «Укрзалізниця».
Всього проведено 42 позапланові заходи державного нагляду (контролю). За результатами проведених перевірок та обстежень винесено 34 приписи, надано рекомендації та направлені рекомендаційні листи керівникам всіх централізованих водопроводів та головам територіальних громад.
Виявлялися невідповідності по санітарно-хімічних показниках в 41-й пробі води та невідповідність по мікробіологічних показниках в 2-х пробах питної води.
При проведенні позапланових заходів за централізованими водопроводами лабораторіями Держпродспоживслужби відібрано 261 пробу води питної: 115 – для дослідження за мікробіологічними, 106 – для дослідження за санітарно-хімічними показниками, 40 – для дослідження за радіологічними показниками. За результатами досліджень 43 проби питної води не відповідали вимогам ДСанПіНу 2.2.4.171-10 «Гігієнічні вимоги до води питної, призначеної для споживання людиною»: 41 – за санітарно-хімічними показниками та 2 проби питної води за мікробіологічними показниками.
Контроль за проведенням оздоровчої кампанії.
В області влітку 2023 року функціонував 51 заклад оздоровлення та відпочинку дітей, із них: 18 стаціонарних, 25 денних (пришкільних) та 8 наметових таборів. За літній період в області всього перебувало 18329 дітей, із них 2070 оздоровлено та 16259 відпочивало.
Спеціалістами Головного управління Держпродспоживслужби в Івано-Франківській області проведено 89 моніторингових обстежень закладів оздоровлення та відпочинку дітей, при яких виявлено 23 порушення (30%) вимог санітарного законодавства. В ході проведеного моніторингу досліджено 29 проб питної води за бактеріологічними та 29 проб води за санітарно-хімічними показниками, 1 проба води за мікробіологічними показниками не відповідала вимогам.
Нагляд за дотриманням санітарного законодавства у закладах освіти. В 2023 році проведено 8 позапланових заходів державного нагляду у сфері санітарного законодавства у закладах загальної середньої освіти. Порушення вимог санітарного законодавства виявлено в 1 з перевірених закладів (надано 1 припис та винесено 1 штраф), що склало 12,5 %. Під час заходів державного нагляду лабораторіями Держпродспоживслужби досліджено 13 зразків готових страв, а саме: 2 зразки – на калорійність, невідповідностей не виявлено; 11 зразків – на мікробіологічні показники, невідповідностей не виявлено; 160 змивів з обладнання, посуду санітарного одягу персоналу на БГКП, невідповідностей не виявлено, 17 проб питної води, невідповідностей не виявлено.
Окрім заходів державного нагляду протягом 2023 року проводились моніторингові обстеження закладів освіти, які працюють в умовах воєнного стану: проведено 1293 моніторингові обстеження закладів освіти, за результатами яких надано 664 рекомендаційні листи.
При підготовці до нового навчального року спеціалісти ГУ ДПСС в Івано-Франківській області брали участь в комісіях по обстеженню укриттів: всього взято участь у 822 моніторингових обстеженнях укриттів у закладах освіти області.
За 2023 рік спеціалістами ГУ ДПСС в Івано-Франківській області розглянуто 1630 примірних чотиритижневих сезонних меню закладів загальної середньої освіти, з яких погоджено 1561 (96%), 69 меню повернуті на доопрацювання, розглянуто 1153 примірних меню закладів дошкільної освіти, погоджено 1108 (95%), 45 меню повернуто на доопрацювання.
Розгляд звернень. Розглянуто 148 звернень громадян щодо порушення санітарних вимог, 74% вирішено на користь заявника.
Надано адміністративних послуг: видано 44 санітарні паспорти на право роботи з іонізуючим випромінюванням, 89 висновків щодо можливості видачі дозволу на викиди забруднюючих речовин в атмосферне повітря, розглянуто 146 проектів генеральних планів населених пунктів та змін до них, видано 8 санітарних паспортів на склади пестицидів та агрохімікатів, погоджено місця видалення відходів – 1.
Спеціалістами Головного управління Держпродспоживслужби в Івано-Франківській області постійно проводиться санітарно-освітня робота з населенням, а саме: на веб-сайти громад та Головного управління Держпродспоживслужби в Івано-Франківській області подано 185 статей, надруковано в періодичній пресі – 18 статей, виступів по ТБ – 7, на радіо – 3, проведено бесід – 3780, лекцій – 84, семінарів-навчань – 40, нарад – 146.
Ініційовано та взято участь в проведенні 79 комісій з питань ТЕБ та НС, де заслуховувалося питання забезпечення санітарного та епідемічного благополуччя населення.

Переглядів: 367


